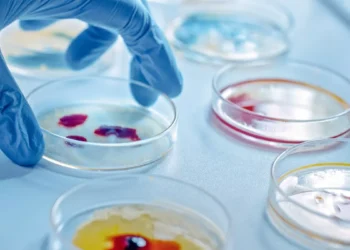
Θλιβερή πρωτιά της Ελλάδας στην ΕΕ σε θανάτους από λοιμώξεις – Το νέο σχέδιο του υπουργείου Υγείας για τα αντιβιοτικά

Θλιβερή πρωτιά της Ελλάδας στην ΕΕ σε θανάτους από λοιμώξεις – Το νέο σχέδιο του υπουργείου Υγείας για τα αντιβιοτικά
Τα αντιβιοτικά αποτελούν μια από τις μεγαλύτερες ανακαλύψεις του 20ου αιώνα, ωστόσο, η αλόγιστη, και πολλές φορές λανθασμένη χρήση τους, ...